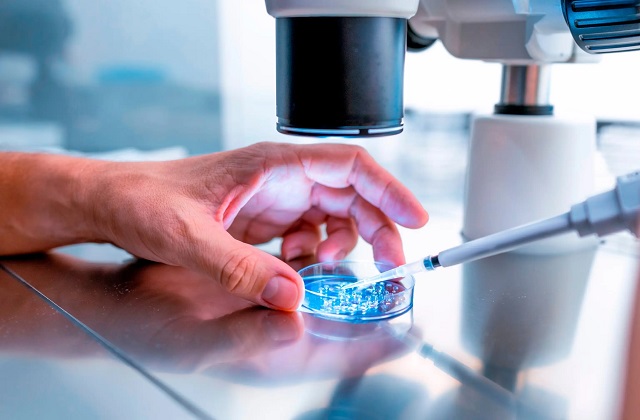
PunjabKesari

नारी डेस्क : मां बनना हर महिला का एक खूबसूरत सपना होता है, लेकिन कई बार स्वास्थ्य कारणों से यह सपना अधूरा रह जाता है। इसी बीच चिकित्सा विज्ञान में एक बड़ी उपलब्धि सामने आई है। राजधानी दिल्ली के सर गंगाराम अस्पताल के डॉक्टरों ने गर्भनाल (Umbilical Cord) से प्राप्त स्टेम सेल की मदद से क्षतिग्रस्त गर्भाशय (यूट्रस) को रिपेयर कर दो महिलाओं को मां बनने में सफल बनाया है। अस्पताल में चल रहे इस विशेष ट्रायल में अब तक 10 महिलाओं को शामिल किया गया है, जिनमें से 2 महिलाएं स्वस्थ बच्चों को जन्म दे चुकी हैं, जबकि अन्य का इलाज अभी जारी है। डॉक्टरों का कहना है कि इस तकनीक से उन महिलाओं के लिए उम्मीद की नई किरण जगी है, जो लंबे समय से गर्भाशय की गंभीर समस्या के कारण मां नहीं बन पा रही थीं।
क्या है यह नई स्टेम सेल थेरेपी
डॉक्टर के अनुसार, कई बार बार-बार गर्भपात (अबॉर्शन) या संक्रमण के कारण गर्भाशय की आंतरिक परत आपस में चिपक जाती है। अबॉर्शन एक ‘ब्लाइंड प्रोसीजर’ होता है, इसलिए कई बार सफाई के दौरान ज्यादा स्क्रैपिंग हो जाती है, जिससे गर्भाशय की परत को नुकसान पहुंचता है और वह ठीक से रिपेयर नहीं हो पाती। इस स्थिति को एशरमैन सिंड्रोम (Asherman Syndrome) कहा जाता है। इसमें महिलाओं के पीरियड्स बंद हो सकते हैं और गर्भधारण करना लगभग असंभव हो जाता है। इसी समस्या का समाधान खोजने के लिए अस्पताल के आईवीएफ (IVF) विभाग और बायोटेक्नोलॉजी एवं रिसर्च विभाग ने मिलकर एक विशेष ट्रायल शुरू किया।

कैसे किया गया इलाज
इस ट्रायल के तहत सिजेरियन डिलीवरी के दौरान मां की अनुमति से गर्भनाल (Umbilical Cord) ली गई। गर्भनाल में मौजूद स्टेम सेल किसी भी अंग की कोशिकाओं की तरह विकसित होने की क्षमता रखते हैं। लैब में तैयार किए गए मेसेनकाइमल स्टेम सेल (UC-MSCs) को वैजाइनल रास्ते से महिलाओं के गर्भाशय में इंजेक्ट किया गया। लगभग 5 से 6 महीनों के भीतर इसका सकारात्मक असर दिखने लगा। जिन दो महिलाओं ने बच्चों को जन्म दिया, उनके पीरियड्स पिछले चार साल से बंद थे, लेकिन इस थेरेपी के बाद उनके पीरियड्स दोबारा शुरू हो गए और गर्भाशय की परत भी सामान्य होने लगी।
39 की उम्र में बांझपन की दी मात
39 वर्षीय एक महिला का गर्भपात होने के बाद उनका गर्भाशय आपस में चिपक गया था। उन्हें स्टेम सेल थेरेपी दी गई, जिसके बाद उनके पीरियड्स फिर से शुरू हो गए और एंडोमेट्रियल मोटाई में सुधार हुआ। इसके बाद आईवीएफ (IVF) तकनीक से एम्ब्रियो ट्रांसफर (Embryo transfer) किया गया। महिला ने गर्भधारण किया और 35 सप्ताह में 2 किलोग्राम वजन वाले स्वस्थ बच्चे को जन्म दिया।

31 सप्ताह में मां बनी
40 वर्षीय दूसरी महिला को बार-बार गर्भपात और गंभीर इंट्रा-यूटेरिन एडहेशन की समस्या थी। उन्हें भी इसी प्रक्रिया से इलाज दिया गया। गर्भाशय की परत में सुधार होने के बाद एम्ब्रियो ट्रांसफर किया गया और उन्होंने 31 सप्ताह में 1.8 किलोग्राम वजन की स्वस्थ बच्ची को जन्म दिया।
नई उम्मीद बनी यह तकनीक
डॉक्टरों का मानना है कि यह तकनीक उन महिलाओं के लिए बेहद उम्मीद भरी है, जो एशरमैन सिंड्रोम (Asherman's Syndrome) या गर्भाशय की गंभीर क्षति के कारण मां नहीं बन पाती थीं। अगर आगे के ट्रायल भी सफल रहते हैं, तो भविष्य में स्टेम सेल थेरेपी बांझपन के इलाज में एक क्रांतिकारी विकल्प साबित हो सकती है।